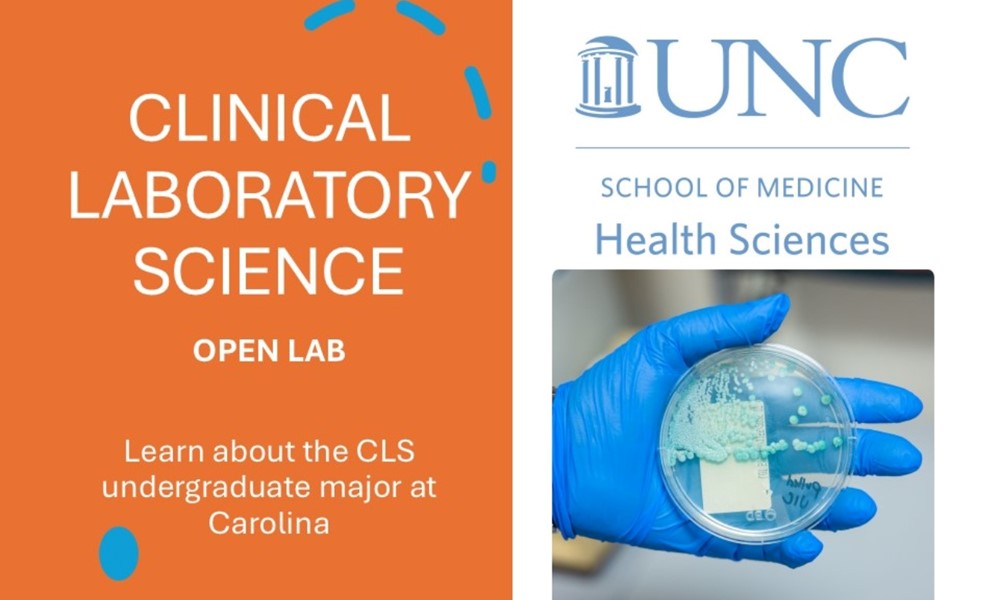

Explore Your Future in Medical Lab Science at the Clinical Laboratory Science Open Lab!
Are you curious about a career in the medical laboratory field? Join us for an immersive experience where you can dive into the world of clinical laboratory science and discover what it’s all about.
What to Expect:
Hands-On Experience: Step into the lab and participate in a real-life simulation exercise that mimics the clinical testing needed for a patient case. You’ll get to work with a case and test samples in four key areas: microbiology, transfusion medicine, hematology, and urinalysis.
Make a Difference: See firsthand how the work done in the lab directly impacts patient care. After the hands-on session, we’ll discuss how the results you produce can influence diagnosis and treatment decisions, ensuring the best outcomes for patients.
Connect with the Pros: Engage in discussions with current medical laboratory professionals, faculty, and students from UNC’s Clinical Laboratory Science program. This is your chance to ask questions, get insights, and explore the variety of career paths available in this dynamic field.
Why Attend?
Whether you’re considering a career in health care or just want to learn more about the role of diagnostic testing in patient care, this Open Lab is the perfect opportunity to get a taste of what it’s like to be a clinical laboratory scientist and earn CLE credit.
Join us and take the first step towards a fulfilling career in the medical laboratory field!
